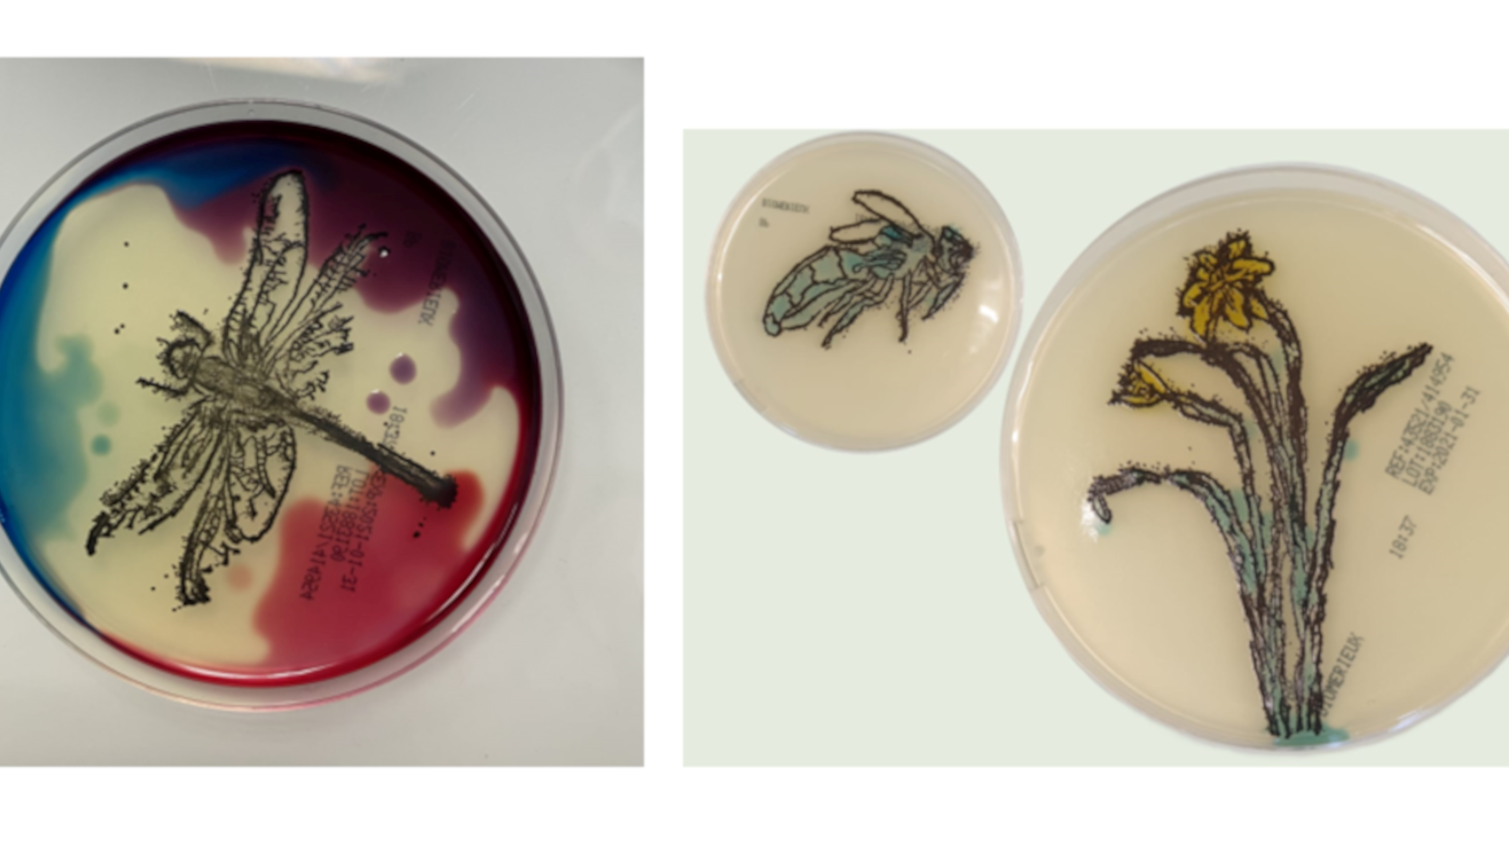

Quand les bactéries font de l’art !
L’Institut Cochin vous propose de découvrir comment les pigments, les propriétés et les différences de composition des bactéries ont été exploités pour leur identification, depuis leur découverte jusqu’à aujourd’hui.
Après une courte exposition, vous pourrez laisser s’exprimer votre créativité au cours d’un atelier artistique « d’agar art » (art sur gélose) en utilisant différentes bactéries qui, après une nuit de culture, révèleront votre talent.
Cet événement est proposé par
- Asmaa Tazi, chercheuse
- Julie Guignot, chercheuse
Public
Accessible à tous
Format
En présentiel
Samedi 15 octobre 2022
Horaires : de 13h30 à 18h
Durée : 1h (8 personnes par créneaux)
Inscription sur place à partir de 13h30
Adresse
